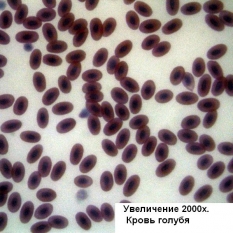

Микроскопы серии B-350 от компании Optika характеризуются оптимальным соотношением цены и качества профессионального лабораторного микроскопа. На базе серии B-350 предлагается широкий выбор светлопольных, темнопольных, поляризационных, фазово-контрастных и флуоресцентных микроскопов. Благодаря разнообразию моделей, приборы этой серии могут использоваться для различных областей профессиональных биологических исследований. Во всех микроскопах серии B-350 применена эффективная система светодиодной подсветки X-LED, являющаяся собственной разработкой компании Optika.
Вся продукция Optika SRL произведена в Италии. В небольшом городке Понтераника (провинция Бергамо) осуществляется разработка, производство и сборка микроскопов Optika. Каждый микроскоп сопровождается индивидуальным серийным номером указанным на корпусе и в гарантийном талоне, а также отметкой о прохождении конечного контроля качества. Все изделия соответствуют основным требованиям соответствующих европейских директив ЕС и стандартам Европейского Союза.
Оптическое разрешение в большей степени зависит от правильного освещения. Современная оптика микроскопов настолько совершенна, что сложно изобрести что-то революционно новое, в то время как скачок развития светодиодных технологий открывает широкие возможности в микроскопии. Компания Optika запатентировала свою революционную разработку предметного светодиодного освещения X-Led. Высокоэффективный светодиод совмещен с рефлектором сложной геометрии и специально спроектированной оптической линзой, что позволяет значительно улучшить интенсивность, однородность и направленность производимого света. В отличии от традиционных галогенных ламп, световой поток, получаемый при использовании системы X-Led обладает ярким белым свечением со световой температурой 6300К, что соответствует естественному дневному освещению. Таким образом, изображение лишено излишне-желтой окраски светом галогенной лампы. Неоспоримым преимуществом является экономичность: энергопотребление светодиода составляет лишь 10% от галогенной лампы аналогичной яркости, при этом срок службы его несравненно выше — 50000 часов по сравнению с 1500 часами галогенной лампы.
Планахромат - это объектив у которого исправлена кривизна поля, хроматическая аберрация и хроматическая разность увеличения. Такая конструкция позволяет производить по одинаковой схеме объективы различных увеличений с одинаково хорошо исправленными аберрациями. Такие объективы дают резкое и четкое изображение по всему полю и как нельзя лучше подходят для микрофотографии. Кроме того, с такими объективами отлично работают широкопольные окуляры.
В оптической системе IOS, скорректированной на бесконечность, световые волны, формирующие изображение объекта, проходят от объектива до линзы тубуса исключительно параллельным пучком. Такая оптическая схема дает два основных преимущества. Во-первых, допускается добавление между объективом и тубусом специальных оптических компонентов (поляризаторы, спектроделители, вертикальные осветители) без изменения оптического пути света. Следовательно не изменяется увеличение, парфокальные свойства объективов, не вносятся дополнительные аберрации от корректирующих элементов. Во-вторых, остаточные геометрические аберрации объектива корректируются оптической линзой тубуса. Изображение четкое и имеет правильное соотношение геометрических размеров. Микроскоп может быть модифицирован для необходимых исследований без потери качества изображения.